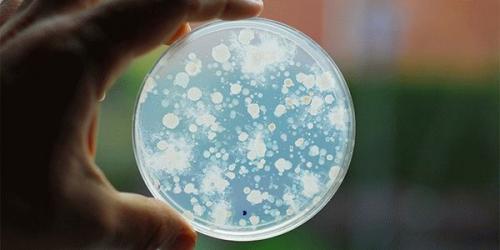
Нити мицелия обнаружены. Нити мицелия 02

Нити мицелия обнаружены. Нити мицелия
Нити мицелия обнаружены. Нити мицелия
Нити мицелия иногда выявляются в мазках или соскобах с кожи, ногтей, половых органов.
Они могут появляться при различных инфекционных заболеваниях, вызванных грибками.
Если выявлены нити мицелия на коже, это признак грибкового её поражения.
У разных грибков мицелий выглядит по-разному.
После микроскопического исследования обычно доктор может определить, какой вид или хотя бы род грибов вызвал воспаление.

Мицелий обнаруживается чаще всего при дерматофитии.
Также может выявляться псевдомицелий.
Его вероятные причины – кандидоз и отрубевидный лишай.
Все эти заболевания имеют грибковое происхождение.
Возможная локализация поражений:
- стопы;
- волосистая часть головы;
- кожные складки;
- половые органы и
- ротовая полость;
- ногти;
- гладкая кожа туловища и конечностей.
Нити мицелия у ребенка на голове
Как у детей, так и у взрослых дерматофиты могут поражать кожу головы.
Это заболевание называют стригущим лишаем.
Характерные признаки:
- очаги облысения;
- нагноение;
- образование узлов;
- шелушение.
Без лечения возможна рубцовая алопеция.
Волосы в зоне локализации рубцов больше не вырастут никогда.
Возбудителем в 90% случаев является Trichophyton tonsurans.
Болеют в основном дети 6-10 лет.
У взрослых патология развивается редко.
Заражаются дети от:
- больных людей;
- животных;
- через загрязненные спорами грибков предметы.

Все грибы, которые могут вызывать заболевание, делятся на эктотриксы и эндотриксы.
Первые поражают мозговое и корковое вещество волосяного стержня.
Гифы попадают в кутикулу, она разрушается.
Эндотриксы кутикулу не повреждают.
Болезнь может сопровождаться себорейным дерматитом.
Осложнения:
- керион – тяжелое воспаление волосяных фолликулов с образованием узлов;
- фавус или парша – на голове появляется твердая корка, болезнь сопровождается рубцеванием.
Мицелий при трихофитии выглядит как сплетение тонких нитей.
Они представляют собой гифы.
Внутри них визуализируются перегородки.
Они называются септами.
Лучше всего мицелий выявляется при обработке раствором КОН с концентрацией от 10 до 30%.
Показан также осмотр под лампой Вуда.
В случае поражения волосистой части головы грибками Microsporum или Trichophyton свечение будет зеленым.
Диагноз может быть подтвержден с помощью культурального метода.
Дерматофиты высеивают на питательные среды.
Для этого используют кожные чешуйки или волосы.
При заборе биоматериала с головы используют щетку.
Ею трут воспаленный участок кожи.
Затем эту щетку прижимают зубчиками к питательной среде.
Используются в основном среды, состоящие из глюкозы, пептона и агар-агара.
При хроническом течении заболевания посевы проводятся ежемесячно.
Дополнительно может применяться патоморфологическое исследование кожи.
Подтвердить грибковую инфекцию позволяет:
- окрашивание по Гомори-Грокотту;
- ШИК-реакция (ткань окрашивается в красный при воздействии на неё йодной кислотой).
Мицелий гриба на коже, что это. Что такое нити мицелия
Структура большинства грибков представлена гифами – одно- или многоклеточными тяжами, совокупность которых составляет тело гриба – мицелий. При попадании спор в благоприятные для прорастания условия происходит их переход в вегетативную форму с развитием нитей септированного мицелия или псевдомицелия. Грибки способны атаковать практически все органы и ткани организма. Самыми распространенными формами заболеваний являются поражения кожи, ногтей, волос, слизистых оболочек.
При микроскопическом исследовании мазка, взятого с пораженной слизистой грибок мицелий лечение на коже и ногтях обнаруживаются гифы мицелия и споры, прозрачность, цвет и особенности строения которых зависят от вида возбудителя. Для слизистых оболочек более характерны оппортунистические микозы (вызванные условно-патогенными грибками): кандидоз, ногтях криптококкоз, аспергиллез и др. Макроскопические признаки поражения слизистых могут быть следующими:
- появляются пятна, налет;
- жжение и зуд;
- неприятный запах;
- появление эрозий, трещин, язв;
- изменение цвета.
Грибки могут поражать как поверхность, так и более глубокие слои кожи. В соответствии с этим микозы подразделяются на поверхностные и кожные. К первым относятся: отрубевидный лишай, черный лишай, себорейный дерматит, белая пьедра, черная пьедра. Группа кожных микозов включает в себя такие заболевания, как микроспория, эпидермофития, трихофития.
Дерматомикозы классифицируются по локализации поражения. Трихофитии подразделяются в зависимости от места развития спор бесполого размножения:
- Эктотрикс. Конидиоспоры образуются на поверхности волоса, возникает повреждение волосяной кутикулы, волос разрушается и выпадает.
- Эндотрикс. Конидии развиваются внутри волоса, кутикула не повреждается. Волос становится ломким, обламывается выше нижней части.
- Фавус (парша). Развитие конидий происходит в основании волоса, вокруг которого образуется круглая чешуйка.
Нити мицелия на коже проявляются:
- образованием видимых колоний грибков;
- гиперемией кожи, появлением пятен;
- ломкостью волос, их выпадением;
- шелушением кожи, появлением перхоти, струпьев, корок, сыпи;
- кожным зудом, при расчесывании пораженных участков кожи возможно присоединение гнойной инфекции.
Нити мицелия на языке особенно часто развиваются вследствие заболевания кандидозом и актиномикозом. Кроме того, могут встречаться случаи аспергиллеза, бластомикоза, споротрихоза и др. Кандидоз языка не является отдельным видом этого заболевания и развивается в рамках поражения полости рта, носоглотки, дыхательных путей. Появляются белые мелкие образования округлой формы, которые впоследствии сливаются с образованием конгломератов. Возникает отек языка, сопровождающийся жжением, болью, нарушениями вкусовой чувствительности.
Грибковые заболевания ногтей носят название онихомикозов. К их числу относятся рубромикоз, ногтевая трихофития и др. Признаками этих разновидностей грибковой инфекции являются:
- изменение цвета ногтя, появление на нем налета, потеря прозрачности;
- расслоение, шелушение;
- изменение структуры ногтя, деформация;
- зуд;
- разрастание ногтевой пластинки.

Нити мицелия на ногтях. Что такое нити мицелия и методы их лечения
Онихомикоз — это грибковая инфекция, поражающая ногтевую пластину и рядом расположенный эпителий. Помимо деформации ногтя, возникают нити мицелия, которые свидетельствуют о наличии серьезных заболеваний. Грибковую инфекцию нельзя оставлять без внимания, т.к. эта патология способна полностью разрушить ноготь и привести к серьезным проблемам. В этой статье мы расскажем о нити мицелия на ногтях. Рассмотрим, что это такое и как лечить этот грибок. Грибок на ногтях достаточно частая инфекция, способная не только ухудшить состояние здоровья, доставить дискомфорт, но и значительно снизить уровень жизни. Возбудителем инфекции являются дерматофиты из семейства Tricophyton. Эти грибки имеют тело мицелий или грибница. Мицелий грибка начинает поражение пластины от свободного края, вследствие чего образуются округлые пятнышки желтого цвета, которые в дальнейшем смешиваются между собой. На фото грибок мицелия на ногтевой пластине Для информации! Грибок задерживается 12 часов на поверхности пластины, затем нити мицелия на ногтях поражают всю площадь и проникают в организм через лимфатическую систему и поражают все органы. Инкубационный период длится несколько недель с момента проникновения инфекции в микротрещину эпителия. После заражения мицелий на ногтях внедряется во все слои пластины, поражает ложе и матрицу, благодаря которой и растет здоровый и правильный ноготь. Стоит отметить, мицелий способен поразить не только ноготь, но и луковицы волос, вследствие чего запускается процесс разложения вещества кератин. Лечение нити мицелия достаточно длительный процесс, с обязательным применением комбинированных и лекарственных препаратов либо с удалением пораженного ногтя хирургическим методом. При несильно пораженной пластине мицелием специалисты назначают лечение при помощи специальных лечебных лаков и гелей, основная задача которых направлена на разрушение клеток грибка, восстановлению и быстрому росту ногтя. Как правило, такая терапия применяется только в случае своевременного обнаружения инфекции, если же болезнь запущена, выполняют хирургическое вмешательство. Для информации! Нити мицелия на ногтях и лечение болезни сопровождается с использованием специального салицилового или трихлоруксусного пластыря. Этиология грибка нити мицелия







Комментарии(1)
Я думаю каждый человек хоть раз в жизни сталкивался с этим самым грибком. Приятного конечно мало. Из всех тех средств что я пробовала, мне больше всего гель мизол нравится. Более того, содержит как раз масло чайного дерева, которое обладает выраженным антисептическим и антибактериальным действием.
Написать комментарий